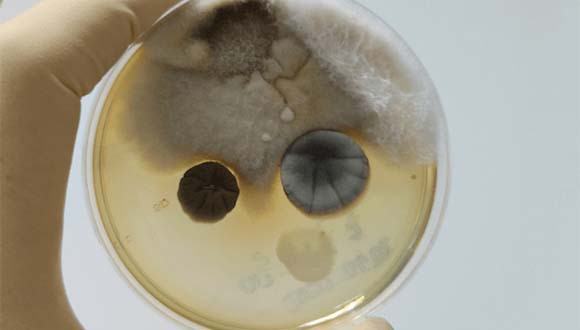
Mold testing services from Creekside Home Inspection Services

Home Inspection Services
Thorough home inspections and easy-to-read reports for both buyers and sellers.
Thorough home inspections and easy-to-read reports for both buyers and sellers.
Gain greater peace of mind and clarity when buying a home, or ensure a smooth transaction with maximum return when selling your home. Additional services include sewer scope inspections and lab analysis of mold samples.

Purchasing a new home also means buying that home's problems. With a pre-purchase home inspection you can see exactly what you're buying. Problems discovered during the inspection could allow you to renegotiate to offset the costs of repairs — potentially saving you thousands of dollars. We'll even help you become familiar with the property.

Sometimes selling your home can be just as much of a roller coaster as buying one. Getting a pre-listing home inspection can help ensure a quick and smooth transaction. You can enter the selling process with confidence that there won't be any unpleasant surprises. You'll also avoid delays, which could last for weeks or even months.

A sewer scope inspection is a video inspection of the sewer line leading from the house to the sewer system or septic tank. We'll check for obstructions, damage, or other issues such as root penetration, holes or cracks, pipe separation, and more. Some issues may not be affecting performance yet but could cause failure later as the problem worsens over time.
If mold is observed during your home inspection, we can collect samples from affected areas and submit them for laboratory analysis. Creekside handles the entire process on your behalf, from collection to interpreting the results, and provides a supplemental report detailing our findings. Standard (4-5 day) and expedited (1-2 day) turnaround options are available to keep your timeline on track.
Check faucets and showers, looking for visible leaks as well as testing water pressure. Identify the types of pipes used, if visible. Identify the location of the main water shutoff valve.
Identify the type of wiring, test a representative number of outlets, and make sure there are GFCIs installed where needed to protect from electrical shock. Inspect the electrical panel for safety issues and fire hazards.
Determine the approximate age of the furnace and air conditioner, whether or not they function properly, and possibly recommend repairs or maintenance.
Determine the approximate age of the water heater and check for proper installation. We can also determine the condition and possibly give an estimated remaining life span of the unit.
Check for proper ventilation. A poorly ventilated dryer exhaust can be a serious fire hazard.
Test smoke detectors and ensure that the garage wall, if present, has the proper fire rating and is undamaged. Also check the fireplace for proper installation and maintenance.
Check for visible leaks, properly secured toilets, proper ventilation to prevent moisture related issues, and more.
If possible, check for structural damage and proper ventilation. Also check insulation and ensure that nothing is ventilated directly into the attic, such as the bathroom.
Check for damaged or missing siding, cracks, and excessive soil contact which can be an invitation for pests.
Check for possible foundation failure, indicated by cracks or settling.
Check to ensure that the ground slopes away from the house, which prevents water from entering the house or causing damage to the foundation.
If accessible and visible, check for roof damage or poor installation that may allow for water penetration as well as checking the condition of the gutters.
Test the garage door for proper functionality, check for proper ventilation to prevent carbon monoxide poisoning, and check for risks of explosion from ignition sources too close to the floor.
Do you have unanswered questions? Or are you ready to schedule your inspection? Either way, we look forward to hearing from you.
Creekside Home Inspection Services proundly serves Pierce, King, Thurston, Lewis, and nearby counties. Give us a call, or send us an email, to confirm service at your location.